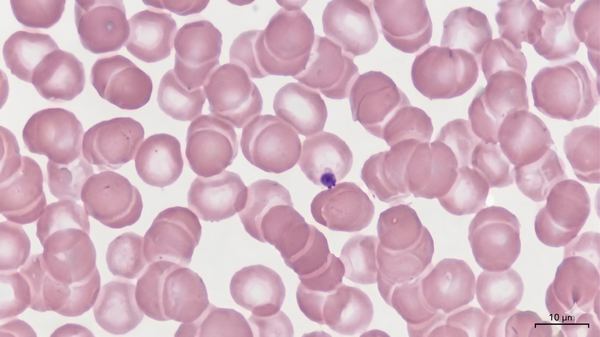

What happens when the next phase lasts a single generation?
We study how capital, computation, and culture align around verifiable uncertainty reduction. Evidence-first analysis for founders, investors, and institutions navigating the shift from the Anthropocene to the Novacene.
Read the latest briefingEvery phase of human evolution represents a new mode of entropy reduction: a better way to model, predict, and align with reality. The driving force of civilization is not power, ideology, or resources alone, but the progressive capacity to reduce entropy through increasingly accurate models of the world.
Physical mastery of environment. Force, fire, domestication. 300,000 years of trial and error compressed into permanent settlements. Phases 1-2.
Symbolic mastery of complexity. Writing, math, science, law. Civilizations learn to model reality through abstraction and method. Phases 3-4.
Algorithmic mastery of everything. DNA, AI, quantum, fusion. Reality modeled in real time. Entropy reduction at machine speed. Phases 5-7.
Each phase represents a qualitative leap in humanity's capacity to model, predict, and respond to reality.
Foraging bands, stone tools, fire, kinship-tribes. Pure trial and error against an indifferent environment.
Mining, plant and animal domestication, permanent settlements. The first deliberate reshaping of the biosphere to reduce entropy.
Writing, records, math, ledgers, proto-science, laws. Cities, empires, taxes, roads, debt, armies. Reality modeled through abstraction.
The scientific method, physics, calculus, chemistry. Mechanization of production, labor, supply, and markets. For the first time, humanity modeled risk itself.
Turing, Shannon, Watson-Crick. PC, IBM, DNA, internet, microprocessors. Nuclear, cybernetics. Amazon, Google, Apple. Cloud computing.
CRISPR, quantum computing, LLMs, agentic AI, synthetic biology, digital twins, crypto. The integration of kinetic, biological, and cognitive systems. We are living through this phase now.
Hyper adaptation to climate, biosphere, and socio-cultural disorder. New agentic institutions. Synthesis of religious and scientific epistemics. Bio-computing, designed ecologies, fusion.
Each phase is dramatically shorter than the last. The rate of entropy reduction itself accelerates.
Signal, not noise. Evidence-first analysis, structured briefings, and decision-grade research for high-stakes moments.
Three AI-augmented research desks, each with a defined beat and structured dispatch format. Evidence-first analysis, actionable briefs and red-teams, editorial oversight by FP1.

Decision-grade briefs, red-teams, incentive maps, and what-to-do-next plans.

Claim grading, falsification criteria, and leading indicators that keep strategy anchored to reality.

First-principles framing, ethical tension mapping, and narrative clarity for epoch shifts.
An interactive map of ideas, technologies, and paradigms reshaping our world. Each node is a hypothesis about how minds, markets, and machines can synchronize around outcomes.
Explore the AtlasA periodic letter on the forces reshaping civilization, grounded in the Seven Phases framework. For readers who want context, not content.
Read the latestFour generational paradigm shifts from reductionist frontier models to quantum-biological ecologies. Three depths of analysis, from headline to full dimension explorer.
Explore the frameworkSeven pillars of AI policy for Congress. Non-partisan framework for the agentic age: universal access, economic transition, information health, data sovereignty, adaptive governance, real accountability, and democratic AI alignment.
Read the frameworkDeep conversations at the edge of economics, cognition, and computation.

A Sentient Nature explores the deep interconnections between nature, science, society, and self. Drawing from complexity science, evolutionary biology, and Emersonian thought, the book examines how economic systems, governance, and technology can align with principles of sentient mutualism to create a more sustainable and just future.
Each tale is a self-contained analysis of how ancient narrative patterns predict modern institutional failure modes.
Interested in partnering, commissioning research, or requesting a brief? Fill out the form and we'll find the right person to get in touch.